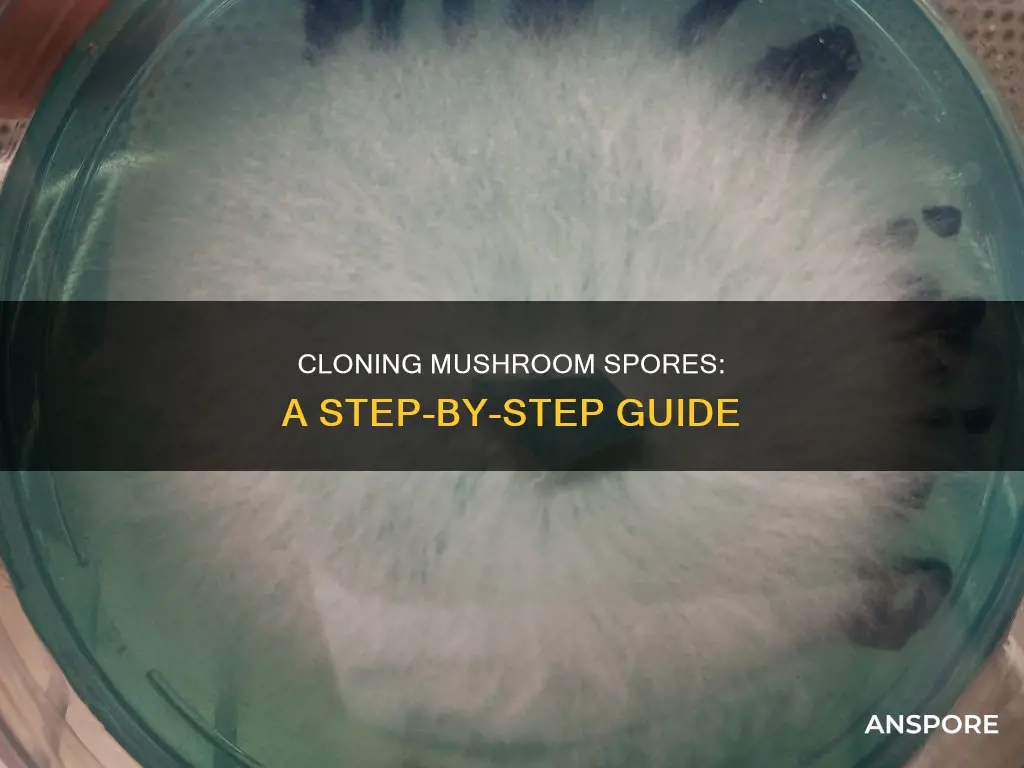
how to clone mushroom spores

Cloning mushrooms is a technique used by mycologists to faithfully reproduce specific mushroom characteristics and maximise crop yields. It involves taking a piece of tissue from an existing fungus and growing it to create a genetically identical copy. This method is particularly useful for preserving the characteristics of exceptional mushrooms and cultivating rare or uncommon strains. Cloning provides consistent and reproducible results, reducing the need to purchase spores or spawn, thereby lowering overall cultivation costs. However, it is important to note that cloning does not produce identical mushrooms indefinitely, as genetic drift and the loss of desirable traits may occur over subsequent generations. To maintain the desired characteristics, fresh genetic material from new specimens or spore prints should be periodically introduced.
| Characteristics | Values |
|---|---|
| Purpose | To faithfully reproduce characteristics of a specific specimen and maximize crop yields |
| Tools | Laminar flow hood, still air box (SAB), Bunsen burner, scalpel, 70% isopropyl alcohol or diluted bleach solution, adhesive tape or parafilm, petri dishes |
| Mushroom selection criteria | Healthy and fully developed, no contamination or disease, fresh, exhibits desired traits such as rapid growth, large fruiting bodies, or high potency |
| Tissue harvesting | Avoid gill tissue due to difficulty in cleaning and presence of spores; recommended sites include stem butt, underneath cap, or center of stem |
| Tissue transfer | Use flame-sterilized scalpel to scrape or cut tissue, quickly transfer to agar plate and close the petri dish to minimize contamination |
| Limitations | Cannot clone mushrooms indefinitely due to genetic drift and potential loss of desirable traits over generations |
Explore related products
What You'll Learn
- Choosing mushrooms to clone: Select healthy, fully-developed mushrooms with desired traits
- Sterilising equipment: Use a laminar flow hood, a still air box, or a Bunsen burner
- Collecting mycelium: Use a flame-sterilised scalpel to cut tissue from the centre of a fresh or dried mushroom
- Storing mushrooms: Store harvested mushrooms in the fridge for up to 48 hours before cloning
- Cloning process: Transfer tissue to a nutrient-rich agar media to initiate mycelium growth

Choosing mushrooms to clone: Select healthy, fully-developed mushrooms with desired traits
When selecting mushrooms to clone, it is essential to choose healthy and fully-developed mushrooms with the desired traits. Avoid specimens that show signs of disease, contamination, or senescence, as these issues may persist in the cloned mycelium and affect the vitality of your mushroom cultures. Choose fresh mushrooms, preferably young mushrooms still in their button stage, as they grow faster and have a higher chance of successful cloning. However, if you must use dried mushrooms, hydrate them with sterilized water first, and proceed with caution and patience.
Select mushrooms with desirable traits such as rapid growth, large fruiting bodies, substrate suitability, disease resistance, or high potency, depending on your specific goals. Look for hardy, fast-growing, and thick-fleshed varieties like oyster, shiitake, or lion's mane mushrooms, which are easier to work with and clone. Choose mushrooms with unique characteristics that you want to faithfully reproduce and maximize your crop yields.
When harvesting reproductive cells, avoid using gill tissue as it is challenging to clean and often contains spores that may lead to the creation of a different strain. Instead, target the stem butt or the middle of the stem, which often contain remnants of mycelium. Additionally, opt for larger mushroom fruiting bodies, as they provide a more substantial tissue sample, making it easier to obtain clean tissue for cloning.
Before cloning, ensure you have a sterile workspace and equipment to minimize contamination. Clean the exterior of the mushroom with a sterilizing agent, such as isopropyl alcohol or a bleach solution, and use a laminar flow hood or a still air box (SAB) to reduce the risk of airborne mold and bacteria spores. By choosing the right mushrooms and maintaining a sterile environment, you can increase your chances of successfully cloning mushrooms with the desired traits.
Mushrooms: Exploring Their Schedule One Status
You may want to see also

Sterilising equipment: Use a laminar flow hood, a still air box, or a Bunsen burner
When cloning mushrooms, it is important to ensure your equipment is sterile to prevent contamination. Here are three methods you can use to sterilise equipment:
Laminar Flow Hood
A laminar flow hood provides a sterile workspace by creating a constant flow of clean air over a workbench. It draws air through a High-Efficiency Particulate Air (HEPA) filter, which removes dust, pollen, mould, bacteria, and spores, and then blows the sterile air into the workspace, pushing contaminated air out.
The typical laminar flow hood consists of three parts: a HEPA filter, a blower fan, and a box to hold it all together. The fan is usually a squirrel cage type blower fan that is mounted on top of the hood, and its performance can be determined by a "performance curve" provided by the manufacturer. For mushroom cultivation, the recommended airflow speed over the workbench is 100 feet per minute.
Still Air Box (SAB)
A still air box is a sterilised workspace that minimises contamination. It can be used as an alternative to a laminar flow hood, especially for those new to mushroom cloning. It is important to clean and sanitise the still air box before use, removing any potential contaminants and wiping down surfaces with a sterilising agent.
Bunsen Burner
A Bunsen burner can be used as a source of direct heat to sterilise equipment and work surfaces. It is important to note that the Bunsen burner does not sterilise the air but provides a localised heat source to work with. When using a Bunsen burner, ensure you are in a well-ventilated area as there is a risk of running out of oxygen.
In addition to these methods, it is important to use sterilising agents such as isopropyl alcohol or a diluted bleach solution to clean equipment and work surfaces before and during the cloning process.
Mushroom Mysteries: Are They Safe?
You may want to see also

Collecting mycelium: Use a flame-sterilised scalpel to cut tissue from the centre of a fresh or dried mushroom
To clone a mushroom, you will need to collect mycelium by cutting tissue from the centre of a fresh or dried mushroom using a flame-sterilised scalpel. Before you begin, ensure that your hands, the scalpel, and any other tools are clean. It is also recommended to wear a face mask, hairnet, and gloves to prevent contaminants from your breath, hair, or hands from landing on the plate.
Firstly, clean the exterior of the mushroom with a sterilising agent such as isopropyl alcohol or a bleach solution. You can also use an alcohol-soaked cloth or paper towel for this step. Avoid cutting the mushroom open, as this can introduce contaminants from the surface to the interior tissue. Instead, gently tear the mushroom open, preferably along the stem, to reveal the sterile tissue inside.
Next, use a flame, such as a butane torch or alcohol lamp, to heat-sterilise your scalpel. Allow the blade to cool briefly before proceeding to avoid damaging the mushroom tissue. You can force the scalpel to cool by dipping it into the clean agar plate before transfer. Once the scalpel is cool, carefully remove a small piece of internal mushroom tissue, about the size of a grain of rice. You can either scrape it or cut a small piece. The thickest, fleshiest part of the mushroom is the easiest to work with.
Finally, transfer the tissue to an agar plate, placing it in the centre of the medium. Some people place more than one piece of tissue in the plate for better chances of success, but it is optional. Close the Petri dish immediately and smoothly to minimise the time the agar plate is open.
Mushrooms: A Complex Composition of Organic Matter
You may want to see also
Explore related products
$7.69

Storing mushrooms: Store harvested mushrooms in the fridge for up to 48 hours before cloning
If you can't clone your mushrooms immediately after harvesting them, you can store them in the fridge for up to 48 hours. It is recommended that you store your mushrooms for as short a time as possible, as it becomes more difficult to germinate mycelium from older mushrooms. The longer you store them, the higher the risk of contamination.
When storing mushrooms, it is important to ensure they are clean. Brush any dirt off the mushrooms and then wash them with water. You can also soak them in hydrogen peroxide for 30 seconds to deactivate any spores of potential contaminants.
There are several ways to store mushrooms before cloning them. One method is to place the mushrooms in a paper bag and then into the fridge. Another method is to cut a small piece of the inner tissue of the mushroom and store it in sterile water in the fridge. You can also store the mushrooms in a Ziploc bag in the fridge.
It is important to note that some mushroom cultures, like pink oyster mushrooms, will not survive if placed in the fridge. Therefore, it is recommended to research the specific storage requirements for your type of mushroom.
Tasty Chinese Mushroom Chicken: A Classic Dish
You may want to see also

Cloning process: Transfer tissue to a nutrient-rich agar media to initiate mycelium growth
Cloning mushrooms is a technique used by mycologists to faithfully reproduce the characteristics of a specific specimen and maximise crop yields. Unlike growing mushrooms from spores, cloning provides consistent and reproducible results.
To clone a mushroom, you need to start by preparing a sterile environment. This is crucial as contamination can ruin your culture. Clean your work area and tools with a sterilising agent like 70% isopropyl alcohol or a diluted bleach solution. You can also use a Bunsen burner to limit contaminants.
Once you have prepared your sterile environment, you can begin the cloning process by transferring tissue to a nutrient-rich agar media to initiate mycelium growth. First, collect a small piece of tissue from the centre of a fresh or dried mushroom using a flame-sterilised scalpel. Avoid using gill tissue as it is often contaminated with spores. The fleshiest and innermost parts of the mushroom, such as the interior of the cap or the stem, are the easiest to work with.
Next, transfer the tissue to a pre-poured or homemade agar plate. Agar is a gelatinous substance derived from red seaweed that provides a sterile environment for mycelium growth. It is also used to identify and remove contamination, ensuring only the healthiest mycelium sectors are selected for cultivation. Place the tissue on the agar plate and close the Petri dish immediately. Seal the plate with parafilm or masking tape to prevent contamination and label it with the date and mushroom strain.
After transferring the tissue to the agar plate, store the plate in a dark, temperature-controlled environment, typically around 70-75°F (21-24°C). Monitor the plate regularly for mycelium growth, which can take anywhere from several days to a few weeks, depending on the strain. As the mycelium grows, keep an eye out for any signs of contamination, such as off-colour growth or unpleasant odours. If only a small portion of the plate is contaminated, you can try to extract a clean sample of mycelium and transfer it to a new, clean plate.
Mushroom and LSD: What's the Connection?
You may want to see also
Frequently asked questions
Cloning provides consistent and reproducible results, allowing you to preserve the characteristics of a specific mushroom specimen. It also reduces costs by decreasing the need to purchase spores or spawn.
Choose a mushroom that is healthy and fully developed. Avoid mushrooms with signs of contamination or disease as these issues may persist in the cloned mycelium. Select mushrooms that exhibit desirable traits such as rapid growth or large fruiting bodies.
You will need a sterile environment, such as a laminar flow hood or a still air box, to prevent contamination. Other required equipment includes a sterile scalpel, sterilisation products like isopropyl alcohol, adhesive tape or parafilm for sealing Petri dishes, and nutrient-rich agar media.
Clean the mushroom with a brush and water, and optionally, immerse it in hydrogen peroxide to deactivate potential contaminants. Using a flame-sterilised scalpel, scrape or cut a small piece of tissue from the mushroom, avoiding the gills due to the risk of spore contamination. Place the tissue onto the agar media quickly to minimise contamination risk.
No, you cannot clone mushrooms forever. With each subsequent cloning generation, the risk of genetic drift and the potential loss of desirable traits increases. To maintain the desired characteristics, periodically introduce fresh genetic material from new specimens or spore prints.











































